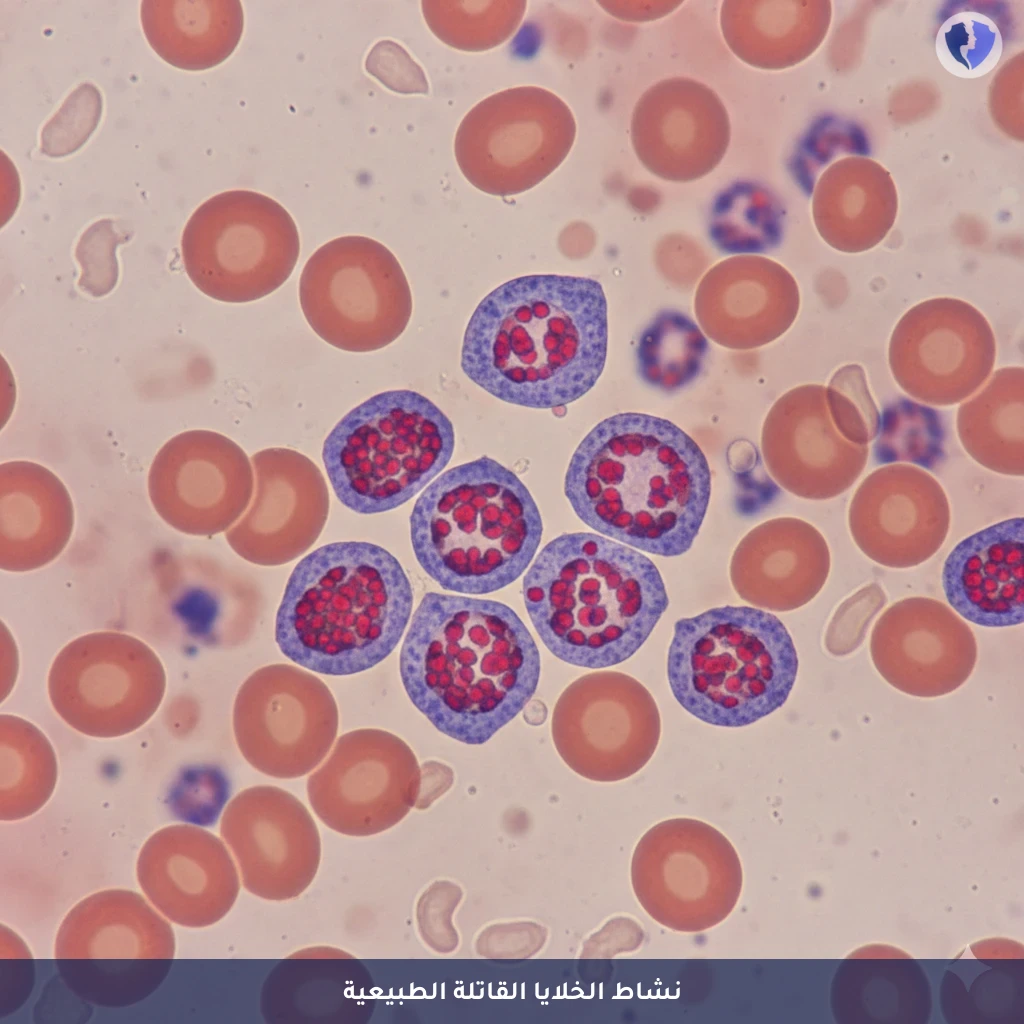
فحص الخلايا القاتلة الطبيعية - تحليل الخلايا القاتلة الطبيعية (CD16/CD56)

تفاصيل الخدمة
فحص الخلايا القاتلة الطبيعية - تحليل الخلايا القاتلة الطبيعية (CD16/CD56)
فحص تدفق خلوي كمي لتعداد وتقييم نشاط الخلايا الليمفاوية القاتلة الطبيعية (NK Cells) في الدم المحيطي. تعبر هذه الخلايا عن العلامات السطحية CD16 وCD56، وتمثل خط الدفاع المناعي الفطري الأولي والمهم ضد الخلايا المصابة بالفيروسات والخلايا السرطانية.